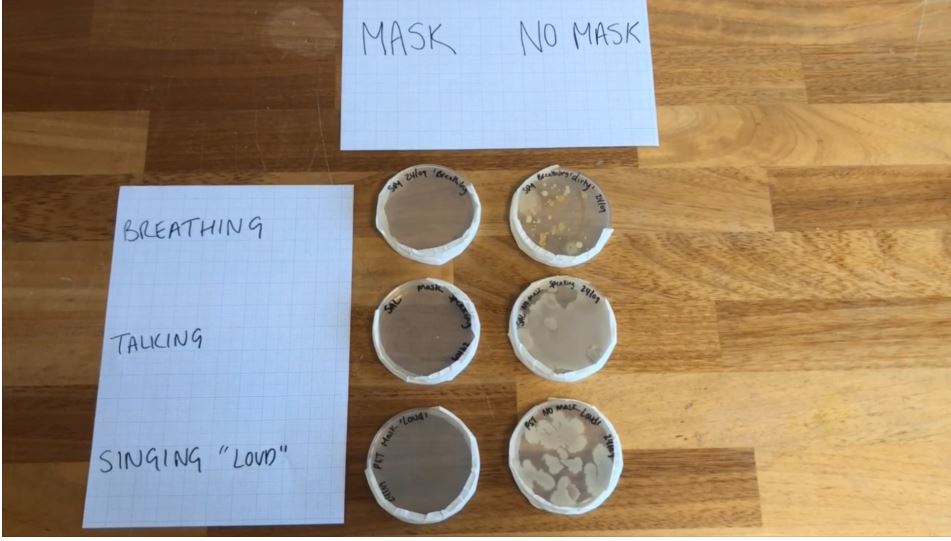
StraUponAvonSch's tweet image. Ever wondered how effective the safety measures we are being asked to do really are? Our Science team have put together a short video demonstrating how these measures really work! vimeo.com/463080158/ada0…

Adam Hodgkinson
@Physicsadam
I teach physics. Assistant Head Learning & Teaching at Stratford Upon Avon School. PiXl science executive group. Interested in co-constructed leadership.
You might like
More of Mr Hodgkinson’s year 12’s exploration of energy stored in springs, energy transfers and the equations of linearly accelerated motion in order to calculate how far their projectiles will travel.
Mr Hodgkinson’s year 12’s combine their knowledge of energy stored in springs, energy transfers and the equations of linearly accelerated motion to calculate how far their projectiles will travel.


Teachers of SuAS go back to the classroom to look at live modelled best practices that form The Stratford Way, expertly led by Mrs Webber, Miss Allso, Mrs Beveridge, Mr Wnuk and Mr Billingham




A huge congratulations to Swan college for their victory today! You can check out our instagram for more highlights from today throughout this week. instagram.com/stratfordupona…

Hello! What would you say makes a great Science curriculum? And how would you ensure that every child in a large MAT had one? Asking for a friend...
Thank you! Teachers are also planning how to assess, reporting their processes, creating the assessments, creating Mark schemes, moderating/standardising the assessments and making grading judgements in addition to their normal workload and whilst paying the exam boards.
Hello @PersimmonHomes the park outside our garden looks like this are you planning to do anything about it?



Hello @PersimmonHomes , out of interest who is responsible for emptying bins on your parks? It's sets a lovely tone for the estate... Bishops gate estate, Warwick.

What's your home teaching look like? I need to make my laptop support more sturdy but this is doing the trick nicely! #Honeteachingsetup

Dear Gavin Williamson. Today I installed a integrated dishwasher, and built the next section of my Lego Apollo 11. Neither task is easy. But I had clear instructions showing what to do, what the end goal looked like and how to build towards it. You should try it one day.


Having watched Zog and the flying Doctors several times with my son's, I assume this is the CPD the government has issued for my return to school as covid tester/vaccination operative?

Ever wondered how effective the safety measures we are being asked to do really are? Our Science team have put together a short video demonstrating how these measures really work! vimeo.com/463080158/ada0…

So the mock election our school held elected another party - does this count now?
One of the perks of this job is the time we get to spend with families in the summer. But if I hear Geoooooorge said with 27 vowels I'm going to spend the rest of my family time with another one

Hello Edutwitter - I've been looking at Ed.Ds - anyone done one? What's the advice?
This morning my 6 y.o sped to school to be first of the queue, then ran in giddy with excitement. Surely this should be a key accountability measure? Good job education, and specifically @Heathcote_P_S.

Now this is a statue! Celebrating when Dannuta Danielsson struck a neo-nazi with her handbag for being a wanker. As we pull down the monuments to imperialist racism what should we replace them with?

United States Trends
- 1. GeForce Season 4,045 posts
- 2. Comey 187K posts
- 3. Everton 145K posts
- 4. St. John 8,600 posts
- 5. Mark Kelly 123K posts
- 6. Amorim 61.9K posts
- 7. #sjubb N/A
- 8. Iowa State 3,519 posts
- 9. Manchester United 84.2K posts
- 10. UCMJ 18.3K posts
- 11. Opus 4.5 9,201 posts
- 12. Seton Hall 2,361 posts
- 13. #LightningStrikes N/A
- 14. 49ers 19.6K posts
- 15. Pickford 11.3K posts
- 16. Benedict Arnold 3,979 posts
- 17. Genesis Mission 2,235 posts
- 18. Dealing 30.5K posts
- 19. Hegseth 48.7K posts
- 20. Lipsey N/A
Something went wrong.
Something went wrong.





































































































